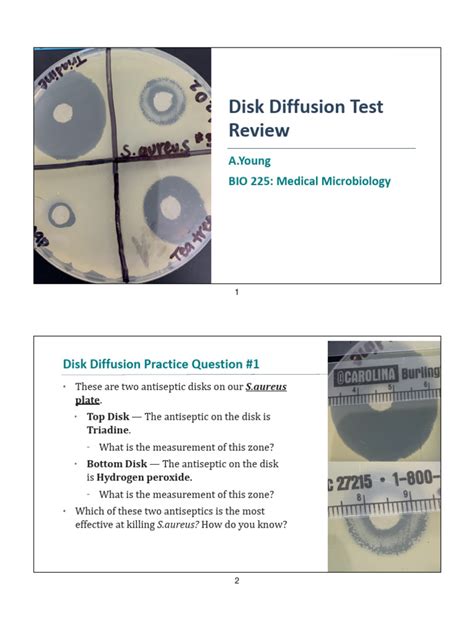

Disk Diffusion Test: Step-by-Step Guide
Disk Diffusion Test: Step-by-Step Guide
The disk diffusion method, also known as the Kirby-Bauer test, is a widely used microbiological assay to determine the antimicrobial susceptibility of bacteria. Guys , if you’re diving into the world of microbiology, understanding this method is crucial. It’s a simple yet powerful technique that helps us figure out which antibiotics will be effective against a specific bacterial infection. Let’s break down the steps in a way that’s easy to follow and understand.
Table of Contents
Preparing for the Disk Diffusion Test
Before you even think about dipping those disks, getting the setup right is super important. Think of it like prepping your ingredients before you start cooking – mess this up, and the whole experiment goes south. First, you need to prepare the bacterial inoculum. This involves selecting a pure culture of the bacteria you want to test. Make sure it’s a pure culture because any contamination will throw off your results. Grow this culture in a suitable broth medium, like Mueller-Hinton broth, until it reaches the logarithmic phase of growth. This is when the bacteria are actively dividing, giving you a good, consistent population to work with. Next, adjust the turbidity of the bacterial suspension to match a 0.5 McFarland standard. This standard ensures that you have a consistent concentration of bacteria in your inoculum. You can use a spectrophotometer to measure the turbidity accurately, or you can visually compare it to the McFarland standard. Remember, consistency is key! Now, let’s talk about the agar plates. You’ll need Mueller-Hinton agar plates, which provide a standardized, nutrient-rich environment for bacterial growth. Pour the agar into sterile petri dishes to a uniform depth of about 4 mm. This depth is crucial because it affects the diffusion of the antibiotics. Allow the agar to solidify completely and then store the plates in a refrigerator until you’re ready to use them. Make sure the agar surface is dry before you inoculate it – excess moisture can interfere with the diffusion of the antibiotics and give you inaccurate results. Finally, gather your antibiotic disks. These disks are small paper disks impregnated with a known concentration of a specific antibiotic. Choose the antibiotics that are relevant to the type of bacteria you’re testing and the infection you’re trying to treat. Store the antibiotic disks according to the manufacturer’s instructions, usually in a refrigerator or freezer, to maintain their potency. With all these steps done right, you’re setting the stage for an accurate and reliable disk diffusion test. It’s all about the prep, friends !
Inoculating the Agar Plate
Okay, everyone , now that your bacterial inoculum and agar plates are prepped, it’s time to get those bacteria onto the plate! This step is crucial for creating a uniform lawn of bacterial growth, which is essential for accurately measuring the zones of inhibition later on. Start by dipping a sterile cotton swab into your standardized bacterial suspension. Make sure to remove any excess liquid by gently pressing the swab against the inside of the tube. You want the swab to be moist but not dripping wet. Next, streak the swab evenly across the entire surface of the Mueller-Hinton agar plate. Rotate the plate approximately 60 degrees and repeat the streaking process. Do this three times to ensure complete and even coverage of the agar surface. This technique, often called lawn inoculation, ensures that you have a consistent layer of bacteria across the entire plate. Aim for confluent growth – that is, a continuous layer of bacteria without any gaps or spaces. If you see any areas that are not covered, gently re-streak those areas with the swab. Once you’ve inoculated the plate, allow it to dry for a few minutes before applying the antibiotic disks. This drying period allows the bacteria to adhere to the agar surface and prevents the disks from sticking to a wet surface, which can affect the diffusion of the antibiotics. Remember, a uniform lawn of bacterial growth is the foundation for a successful disk diffusion test. Take your time, be thorough, and pay attention to detail. If you mess up the inoculation, it’s better to start over with a fresh plate than to proceed with unreliable results. This meticulous approach will pay off when you’re interpreting the zones of inhibition and determining the antibiotic susceptibility of the bacteria.
Applying Antibiotic Disks
Alright, folks , with your inoculated agar plate drying, it’s showtime for the antibiotic disks! This is where the magic happens, as these little disks will determine which antibiotics can kick those bacteria to the curb. Grab your sterile forceps or a disk dispenser, and carefully pick up each antibiotic disk. Gently press the disk onto the surface of the agar, ensuring good contact. You want the disk to adhere to the agar without sinking into it. Space the disks evenly around the plate, leaving enough room between them to prevent overlapping zones of inhibition. A good rule of thumb is to keep about 24 mm between the disks. This spacing allows you to clearly measure the diameter of each zone without any interference from neighboring antibiotics. Avoid placing disks too close to the edge of the plate, as this can lead to inaccurate results due to edge effects. Once you’ve applied all the antibiotic disks, gently tap each one again to ensure it’s firmly in place. This step is crucial for optimal diffusion of the antibiotics into the agar. After applying the disks, invert the plate and incubate it at the appropriate temperature for the bacteria you’re testing. Typically, this is 35-37°C for most common bacteria, but make sure to consult the guidelines for your specific organism. The incubation period is usually 16-18 hours, allowing enough time for the antibiotics to diffuse and inhibit bacterial growth. Remember, proper placement and spacing of the antibiotic disks are essential for accurate results. Take your time, be precise, and pay attention to detail. This meticulous approach will help you confidently interpret the zones of inhibition and determine the antibiotic susceptibility of the bacteria. Now, let’s pop those plates into the incubator and let the antibiotics do their thing!
Incubating the Agar Plate
Time to tuck those inoculated plates into a warm, cozy incubator! Proper incubation is super important for getting accurate results in your disk diffusion test. Think of it like baking a cake – you need the right temperature and time to get it just right. So, invert your plates (agar side up) to prevent condensation from dripping onto the agar surface. Condensation can mess with the diffusion of antibiotics and give you wonky results. Place the inverted plates in an incubator set at the optimal temperature for the bacteria you’re testing. For most common bacteria, like E. coli or Staphylococcus aureus , 35-37°C is the sweet spot. But remember, some bacteria have different temperature preferences, so always check the guidelines for your specific organism. Now, let the plates incubate for the recommended time, usually 16-18 hours. This incubation period allows the antibiotics to diffuse into the agar and inhibit the growth of susceptible bacteria. During this time, the bacteria will multiply and form a lawn of growth, except in the areas where the antibiotics are effective. It’s tempting to peek at the plates before the incubation period is over, but resist the urge! Premature observation can lead to inaccurate interpretations. Once the incubation period is complete, carefully remove the plates from the incubator and get ready to examine them. You’ll be looking for those clear zones of inhibition around the antibiotic disks, which indicate the antibiotics that are effective against the bacteria. Remember, consistent temperature and incubation time are crucial for reliable results. So, set your incubator properly, be patient, and let the magic happen!
Measuring Zones of Inhibition
Alright, everyone , the incubation is done, and it’s time to measure those zones of inhibition! This is where you’ll see which antibiotics have successfully put a stop to the bacterial growth. Grab a ruler or, even better, a pair of calipers, and get ready to measure the diameter of each zone of inhibition in millimeters. Hold the ruler or calipers on the back of the plate, if that gives you a clearer view. Make sure you’re measuring the entire zone, including the diameter of the disk itself. The zone of inhibition is the clear area around the antibiotic disk where the bacteria haven’t grown. It indicates the antibiotic’s ability to inhibit or kill the bacteria. Measure each zone carefully and record the measurements accurately. If the zone is not perfectly circular, measure the diameter at the widest point. Be sure to measure from the back of the plate! For accuracy, good lighting is key, so make sure you are working in a well-lit area to avoid shadows or visual distortions. Double-check each measurement to minimize errors. Accurate measurements are crucial for proper interpretation of the results. Compare your measurements to standardized tables provided by organizations like the Clinical and Laboratory Standards Institute (CLSI). These tables provide interpretive criteria for each antibiotic, allowing you to classify the bacteria as susceptible, intermediate, or resistant to each antibiotic. By carefully measuring the zones of inhibition and comparing them to standardized tables, you can confidently determine the antibiotic susceptibility of the bacteria and guide appropriate treatment decisions. So, take your time, be precise, and measure those zones like a pro!
Interpreting Results
Now comes the exciting part – figuring out what those measurements actually mean ! You’ve got your zones of inhibition measured, and now it’s time to translate those numbers into actionable information about antibiotic susceptibility. Remember those standardized tables we talked about? Dust them off, because you’re going to need them. These tables, typically provided by the Clinical and Laboratory Standards Institute (CLSI), list the interpretive criteria for each antibiotic. They’ll tell you the diameter breakpoints that define whether a bacterium is susceptible, intermediate, or resistant to a particular antibiotic. To interpret your results, simply compare the diameter of each zone of inhibition to the corresponding breakpoint in the table. If the zone diameter is equal to or greater than the susceptible breakpoint, the bacteria are considered susceptible to that antibiotic. This means the antibiotic is likely to be effective in treating an infection caused by that bacteria. If the zone diameter falls within the intermediate range, the bacteria are considered intermediate in their susceptibility to the antibiotic. This means the antibiotic may be effective at higher doses or in specific locations in the body, but it’s not as reliable as a susceptible result. If the zone diameter is equal to or less than the resistant breakpoint, the bacteria are considered resistant to that antibiotic. This means the antibiotic is unlikely to be effective in treating an infection caused by that bacteria. Keep in mind that interpretation can be affected by many factors, including the depth of the agar and the density of the inoculum. Be sure to follow standard procedures! Once you’ve interpreted the results for each antibiotic, you can create an antibiogram, which is a summary of the antibiotic susceptibility profile of the bacteria. This information is invaluable for clinicians in selecting the most appropriate antibiotic treatment for a patient. It helps them avoid prescribing antibiotics that are unlikely to be effective and reduces the risk of antibiotic resistance. So, take your time, consult those standardized tables, and interpret your results carefully. Your accurate interpretation can make a real difference in patient care!